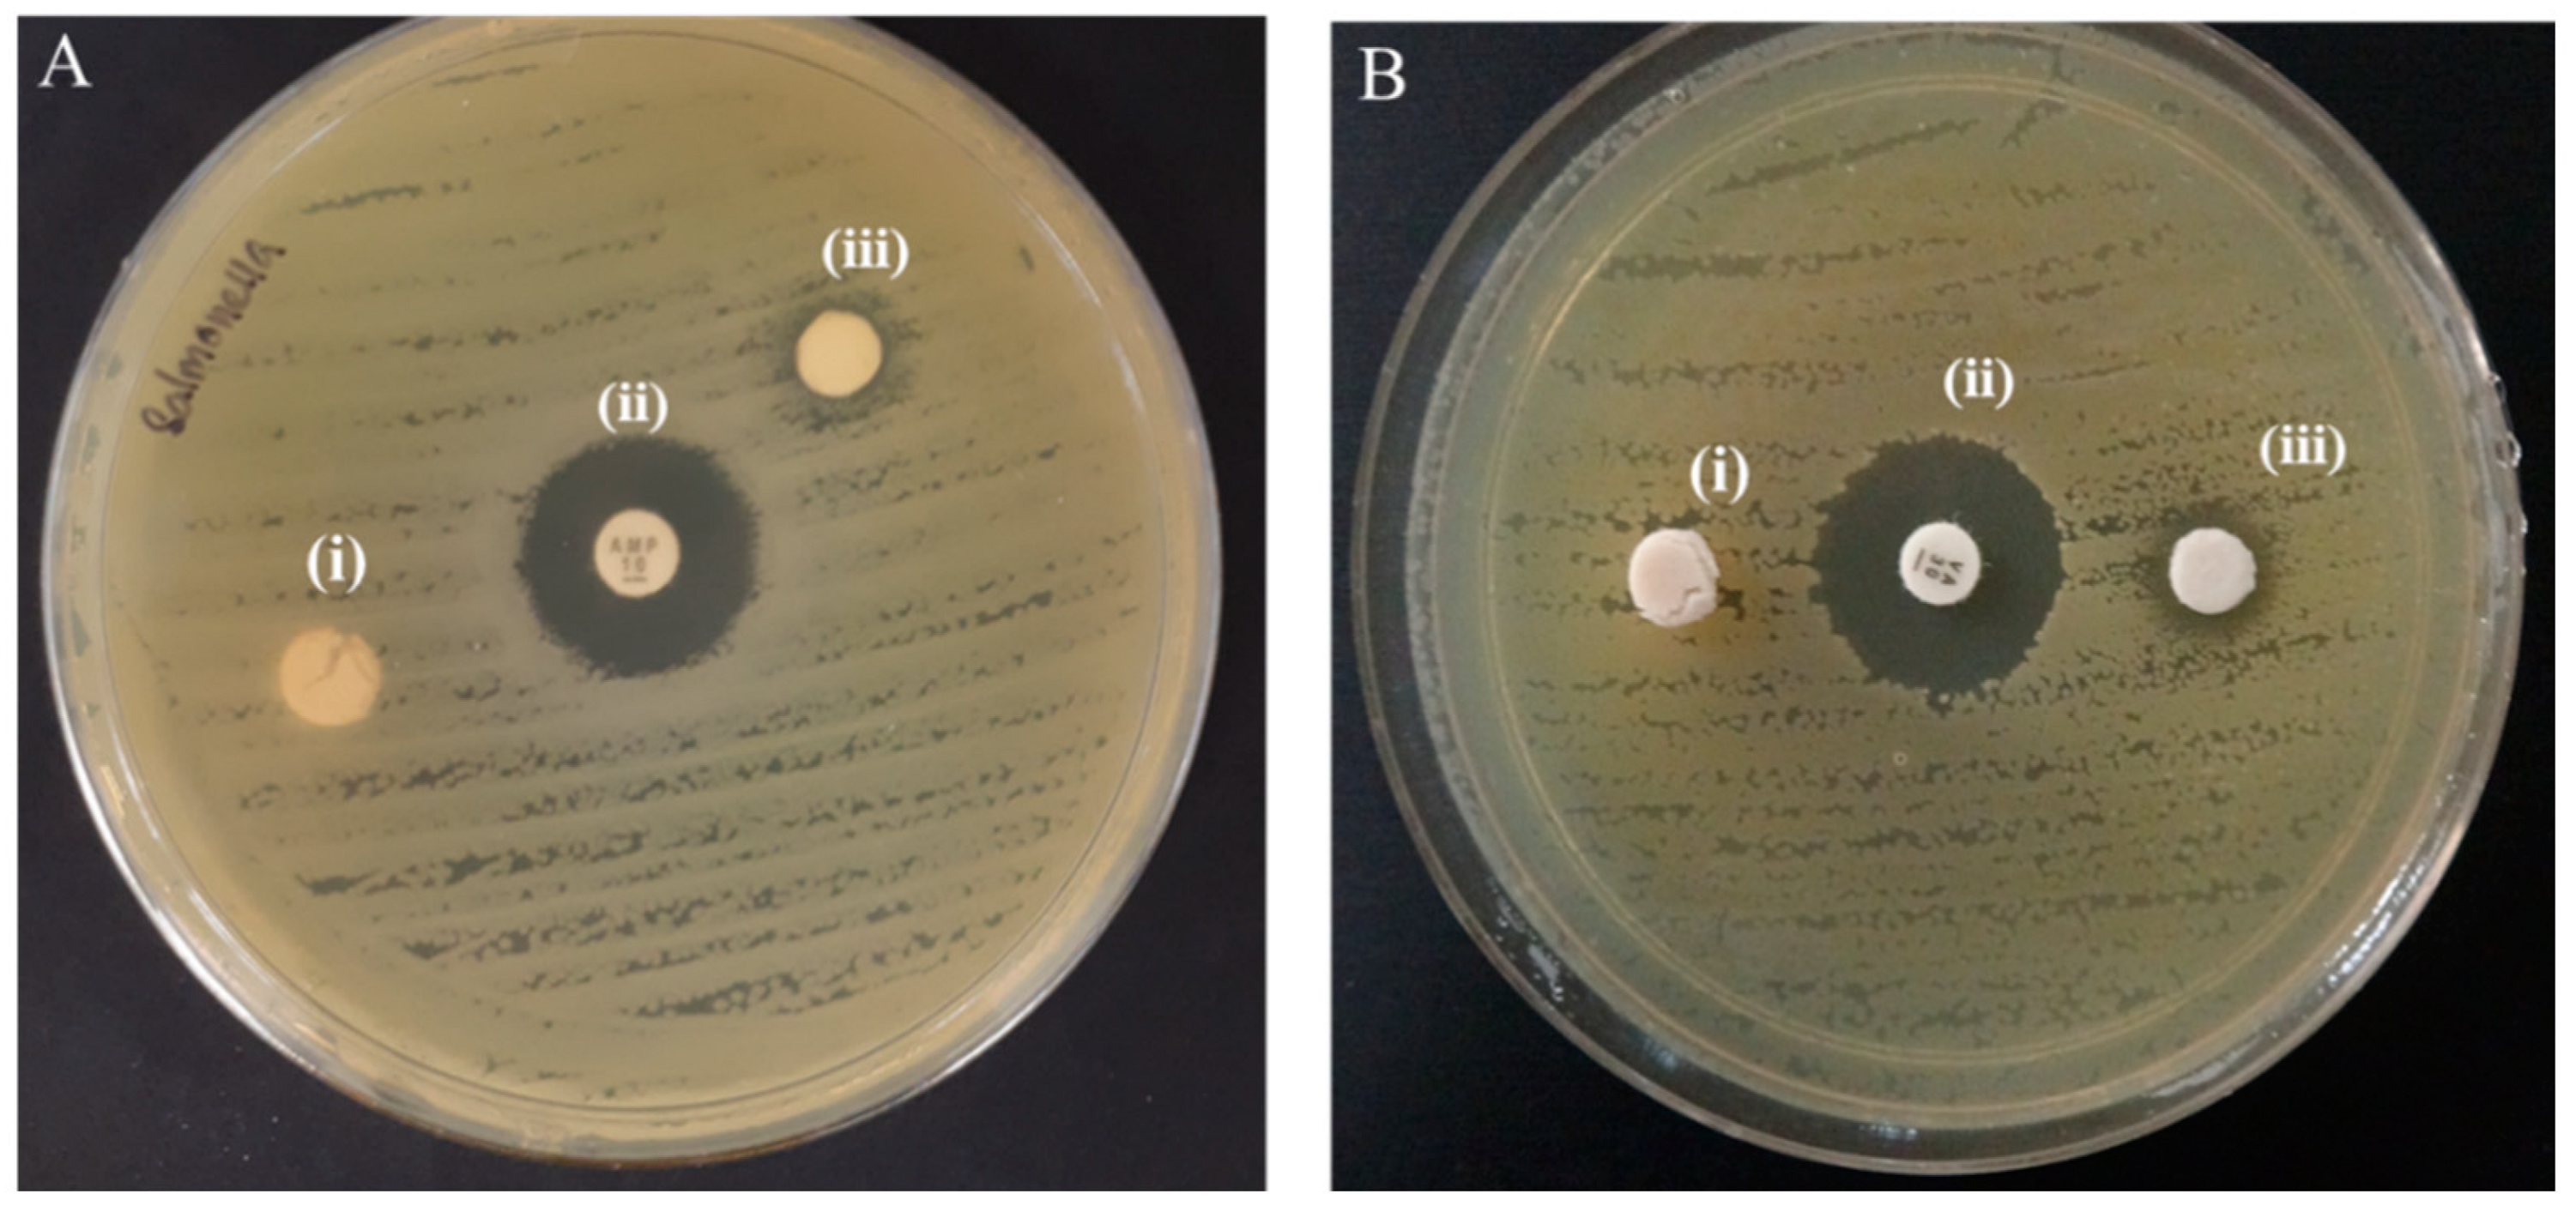
Ijms 22 05781 g006 Ijms 22 05781 g006

Facile Synthesis and Characterization of Palm CNF-ZnO Nanocomposites with Antibacterial and Reinforcing Properties
Abstract
1. Introduction
2. Results and Discussions
2.1. Formation Mechanism of ZnO NPs on CNF Matrix
2.2. Morphology of CNF-ZnO Nanocomposite
2.3. Chemical Composition of CNF-ZnO Nanocomposite
2.4. Thermal Behavior of the CNF-ZnO Nanocomposite
2.5. Release Properties of Zn2+ from the CNF-ZnO Nanocomposite
2.6. Antibacterial Activity of CNF-ZnO Nanocomposite
2.7. Tensile Strength and Heat Resistance Characteristics of NR/CNF-ZnO Composite Film
3. Materials and Methods
3.1. Materials
3.2. Sonochemical Preparation of CNF-ZnO Nanocomposite
3.3. Fabrication of NR/CNF-ZnO Composite Film
3.4. Characterization of Synthesized CNF-ZnO Nanocomposite
3.5. Antibacterial Assay
3.6. Tensile Tests of NR Composite Films
4. Conclusions
Supplementary Materials
Author Contributions
Funding
Institutional Review Board Statement
Informed Consent Statement
Data Availability Statement
Acknowledgments
Conflicts of Interest
References
- Sharma, A.; Thakur, M.; Bhattacharya, M.; Mandal, T.; Goswami, S. Commercial application of cellulose nano-composites—A review. Biotechnol. Rep. 2019, 21, e00316. [Google Scholar] [CrossRef] [PubMed]
- Tuerxun, D.; Pulingam, T.; Nordin, N.I.; Chen, Y.W.; Kamaldin, J.B.; Julkapli, N.B.M.; Lee, H.V.; Leo, B.F.; Johan, M.R.B. Synthesis, characterization and cytotoxicity studies of nanocrystalline cellulose from the production waste of rubber-wood and kenaf-bast fibers. Eur. Polym. J. 2019, 116, 352–360. [Google Scholar] [CrossRef]
- Juncos Bombin, A.D.; Dunne, N.J.; McCarthy, H.O. Electrospinning of natural polymers for the production of nanofibres for wound healing applications. Mater. Sci. Eng. C 2020, 114, 110994. [Google Scholar] [CrossRef] [PubMed]
- Singh, A.; Walker, K.T.; Ledesma-Amaro, R.; Ellis, T. Engineering bacterial cellulose by synthetic biology. Int. J. Mol. Sci. 2020, 21, 9185. [Google Scholar] [CrossRef] [PubMed]
- Low, D.Y.S.; Supramaniam, J.; Soottitantawat, A.; Charinpanitkul, T.; Tanthapanichakoon, W.; Tan, K.W.; Tang, S.Y. Recent developments in nanocellulose-reinforced rubber matrix composites: A review. Polymers 2021, 13, 550. [Google Scholar] [CrossRef]
- Awalludin, M.F.; Sulaiman, O.; Hashim, R.; Nadhari, W.N.A.W. An overview of the oil palm industry in Malaysia and its waste utilization through thermochemical conversion, specifically via liquefaction. Renew. Sustain. Energy Rev. 2015, 50, 1469–1484. [Google Scholar] [CrossRef]
- Derman, E.; Abdulla, R.; Marbawi, H.; Sabullah, M.K. Oil palm empty fruit bunches as a promising feedstock for bioethanol production in Malaysia. Renew. Energy 2018, 129, 285–298. [Google Scholar] [CrossRef]
- Ariffin, M.A.; Wan Mahmood, W.M.F.; Harun, Z.; Mohamed, R. Medium-scale gasification of oil palm empty fruit bunch for power generation. J. Mater. Cycles Waste Manag. 2017, 19, 1244–1252. [Google Scholar] [CrossRef]
- Chowdhury, M.N.K.; Beg, M.D.H.; Khan, M.R.; Mina, M.F. Modification of oil palm empty fruit bunch fibers by nanoparticle impregnation and alkali treatment. Cellulose 2013, 20, 1477–1490. [Google Scholar] [CrossRef]
- Li, Y.; Sun, H.; Zhang, Y.; Xu, M.; Shi, S.Q. The three-dimensional heterostructure synthesis of ZnO/cellulosic fibers and its application for rubber composites. Comp. Sci. Tech. 2019, 177, 10–17. [Google Scholar] [CrossRef]
- Bacakova, L.; Pajorova, J.; Bacakova, M.; Skogberg, A.; Kallio, P.; Kolarova, K.; Svorcik, V. Versatile application of nanocellulose: From industry to skin tissue engineering and wound healing. Nanomaterials 2019, 9, 164. [Google Scholar] [CrossRef]
- Xu, X.; Liu, F.; Jiang, L.; Zhu, J.Y.; Haagenson, D.; Wiesenborn, D.P. Cellulose nanocrystals vs. cellulose nanofibrils: A comparative study on their microstructures and effects as polymer reinforcing agents. ACS Appl. Mater. Interfaces 2013, 5, 2999–3009. [Google Scholar] [CrossRef]
- Shahmohammadi Jebel, F.; Almasi, H. Morphological, physical, antimicrobial and release properties of ZnO nanoparticles-loaded bacterial cellulose films. Carbohydr. Polym. 2016, 149, 8–19. [Google Scholar] [CrossRef]
- Abdalkarim, S.Y.H.; Yu, H.-Y.; Wang, C.; Yang, L.; Guan, Y.; Huang, L.; Yao, J. Sheet-like cellulose nanocrystal-ZnO nanohybrids as multifunctional reinforcing agents in biopolyester composite nanofibers with ultrahigh UV-shielding and antibacterial performances. ACS Appl. Bio Mater. 2018, 1, 714–727. [Google Scholar] [CrossRef]
- Singh, R.; Dutta, S. The role of pH and nitrate concentration in the wet chemical growth of nano-rods shaped ZnO photocatalyst. Nano-Struct. Nano-Objects 2019, 18, 100250. [Google Scholar] [CrossRef]
- Ashraf, R.; Riaz, S.; Hussain, S.S.; Naseem, S. Effect of pH on properties of ZnO nanoparticles. Mater. Today Proc. 2015, 2, 5754–5759. [Google Scholar] [CrossRef]
- Muller, K.; Bugnicourt, E.; Latorre, M.; Jorda, M.; Echegoyen Sanz, Y.; Lagaron, J.M.; Miesbauer, O.; Bianchin, A.; Hankin, S.; Bolz, U.; et al. Review on the Processing and properties of polymer nanocomposites and nanocoatings and their applications in the packaging, automotive and solar energy fields. Nanomaterials 2017, 7, 74. [Google Scholar] [CrossRef]
- Varaprasad, K.; Raghavendra, G.M.; Jayaramudu, T.; Seo, J. Nano zinc oxide–sodium alginate antibacterial cellulose fibres. Carbohydr. Polym. 2016, 135, 349–355. [Google Scholar] [CrossRef] [PubMed]
- Lefatshe, K.; Muiva, C.M.; Kebaabetswe, L.P. Extraction of nanocellulose and in-situ casting of ZnO/cellulose nanocomposite with enhanced photocatalytic and antibacterial activity. Carbohydr. Polym. 2017, 164, 301–308. [Google Scholar] [CrossRef]
- Katepetch, C.; Rujiravanit, R.; Tamura, H. Formation of nanocrystalline ZnO particles into bacterial cellulose pellicle by ultrasonic-assisted in situ synthesis. Cellulose 2013, 20, 1275–1292. [Google Scholar] [CrossRef]
- Aladpoosh, R.; Montazer, M. The role of cellulosic chains of cotton in biosynthesis of ZnO nanorods producing multifunctional properties: Mechanism, characterizations and features. Carbohydr. Polym. 2015, 126, 122–129. [Google Scholar] [CrossRef]
- Wahab, R.; Ansari, S.G.; Kim, Y.S.; Song, M.; Shin, H.-S. The role of pH variation on the growth of zinc oxide nanostructures. Appl. Surf. Sci. 2009, 255, 4891–4896. [Google Scholar] [CrossRef]
- Oskam, G. Metal oxide nanoparticles: Synthesis, characterization and application. J. Sol.-Gel Sci. Technol. 2006, 37, 161–164. [Google Scholar] [CrossRef]
- Bian, S.-W.; Mudunkotuwa, I.A.; Rupasinghe, T.; Grassian, V.H. Aggregation and dissolution of 4 nm ZnO nanoparticles in aqueous environments: Influence of pH, ionic strength, size, and adsorption of humic acid. Langmuir 2011, 27, 6059–6068. [Google Scholar] [CrossRef]
- Zhang, Y.; Chen, Y.; Westerhoff, P.; Hristovski, K.; Crittenden, J.C. Stability of commercial metal oxide nanoparticles in water. Water Res. 2008, 42, 2204–2212. [Google Scholar] [CrossRef] [PubMed]
- Zheng, M.; Wang, P.-L.; Zhao, S.-W.; Guo, Y.-R.; Li, L.; Yuan, F.-L.; Pan, Q.-J. Cellulose nanofiber induced self-assembly of zinc oxide nanoparticles: Theoretical and experimental study on interfacial interaction. Carbohydr. Polym. 2018, 195, 525–533. [Google Scholar] [CrossRef] [PubMed]
- Zhao, S.-W.; Zheng, M.; Zou, X.-H.; Guo, Y.; Pan, Q.-J. Self-assembly of hierarchically structured Cellulose@ZnO composite in solid–liquid homogeneous phase: Synthesis, DFT calculations, and enhanced antibacterial activities. ACS Sustain. Chem. Eng. 2017, 5, 6585–6596. [Google Scholar] [CrossRef]
- Janpetch, N.; Saito, N.; Rujiravanit, R. Fabrication of bacterial cellulose-ZnO composite via solution plasma process for antibacterial applications. Carbohydr. Polm. 2016, 148, 335–344. [Google Scholar] [CrossRef]
- Ko, H.-U.; Mun, S.; Min, S.-K.; Kim, G.-W.; Kim, J. Fabrication of cellulose ZnO hybrid nanocomposite and its strain sensing behavior. Materials 2014, 7, 7000–7009. [Google Scholar] [CrossRef] [PubMed]
- Fu, F.; Li, L.; Liu, L.; Cai, J.; Zhang, Y.; Zhou, J.; Zhang, L. Construction of cellulose based ZnO nanocomposite films with antibacterial properties through one-step coagulation. ACS Appl. Mater. Interfaces 2015, 7, 2597–2606. [Google Scholar] [CrossRef] [PubMed]
- Shayegan Mehr, E.; Sorbiun, M.; Ramazani, A.; Taghavi Fardood, S. Plant-mediated synthesis of zinc oxide and copper oxide nanoparticles by using ferulago angulata (schlecht) boiss extract and comparison of their photocatalytic degradation of Rhodamine B (RhB) under visible light irradiation. J. Mater. Sci. Mater. Electron. 2018, 29, 1333–1340. [Google Scholar] [CrossRef]
- Taghavi Fardood, S.; Ramazani, A.; Moradi, S.; Azimzadeh Asiabi, P. Green synthesis of zinc oxide nanoparticles using arabic gum and photocatalytic degradation of direct blue 129 dye under visible light. J. Mater. Sci. Mater. Electron. 2017, 28, 13596–13601. [Google Scholar] [CrossRef]
- Li, X.; Zhang, J.; Ju, Z.; Li, Y.; Xu, J.; Xin, J.; Lu, X.; Zhang, S. Facile synthesis of cellulose/ZnO aerogel with uniform and tunable nanoparticles based on ionic liquid and polyhydric alcohol. ACS Sustain. Chem. Eng. 2018, 6, 16248–16254. [Google Scholar] [CrossRef]
- Wang, S.; Yang, Y.; Lu, A.; Zhang, L. Construction of cellulose/ZnO composite microspheres in NaOH/zinc nitrate aqueous solution via one-step method. Cellulose 2019, 26, 557–568. [Google Scholar] [CrossRef]
- George, D.; Maheswari, P.U.; Begum, K.M.M.S. Chitosan-cellulose hydrogel conjugated with L-histidine and zinc oxide nanoparticles for sustained drug delivery: Kinetics and in-vitro biological studies. Carbohydr. Polym. 2020, 236, 116101. [Google Scholar] [CrossRef]
- Yadollahi, M.; Gholamali, I.; Namazi, H.; Aghazadeh, M. Synthesis and characterization of antibacterial carboxymethyl cellulose/ZnO nanocomposite hydrogels. Int. J. Biol. Macromol. 2015, 74, 136–141. [Google Scholar] [CrossRef] [PubMed]
- Liu, P.; Maolin, Z.; Li, J.; Peng, J.; Wu, J. Radiation preparation and swelling behavior of sodium carboxymethyl cellulose hydrogels. Radiat. Phys. Chem. 2002, 63, 525–528. [Google Scholar] [CrossRef]
- Shah, R.; Saha, N.; Saha, P. Influence of temperature, pH and simulated biological solutions on swelling and structural properties of biomineralized (CaCO3) PVP–CMC hydrogel. Prog. Biomater. 2015, 4, 123–136. [Google Scholar] [CrossRef]
- Khan, R.; Inam, M.A.; Zam, S.Z.; Park, D.R.; Yeom, I.T. Assessment of key environmental factors influencing the sedimentation and aggregation behavior of zinc oxide nanoparticles in aquatic environment. Water 2018, 10, 660. [Google Scholar] [CrossRef]
- Sportelli, M.C.; Picca, R.A.; Paladini, F.; Mangone, A.; Giannossa, L.C.; Franco, C.D.; Gallo, A.L.; Valentini, A.; Sannino, A.; Pollini, M.; et al. Spectroscopic characterization and nanosafety of Ag-modified antibacterial leather and leatherette. Nanomaterials 2017, 7, 203. [Google Scholar] [CrossRef]
- Borda d’Água, R.; Branquinho, R.; Duarte, M.P.; Maurício, E.; Fernando, A.L.; Martins, R.; Fortunato, E. Efficient coverage of ZnO nanoparticles on cotton fibres for antibacterial finishing using a rapid and low cost in situ synthesis. New J. Chem. 2018, 42, 1052–1060. [Google Scholar] [CrossRef]
- Espitia, P.J.P.; Soares, N.d.F.F.; Coimbra, J.S.d.R.; de Andrade, N.J.; Cruz, R.S.; Medeiros, E.A.A. Zinc oxide nanoparticles: Synthesis, antimicrobial activity and food packaging applications. Food Bioproc. Tech. 2012, 5, 1447–1464. [Google Scholar] [CrossRef]
- Russell, A.D. Similarities and differences in the responses of microorganisms to biocides. J. Antimicrob. Chemother. 2003, 52, 750–763. [Google Scholar] [CrossRef] [PubMed]
- Silhavy, T.J.; Kahne, D.; Walker, S. The bacterial cell envelope. Cold Spring Harb. Perspect. Biol. 2010, 2, a000414. [Google Scholar] [CrossRef]
- Li, Y.; Zhang, W.; Niu, J.; Chen, Y. Mechanism of photogenerated reactive oxygen species and correlation with the antibacterial properties of engineered metal-oxide nanoparticles. ACS Nano 2012, 6, 5164–5173. [Google Scholar] [CrossRef] [PubMed]
- Mahamuni-Badiger, P.P.; Patil, P.M.; Badiger, M.V.; Patel, P.R.; Thorat-Gadgil, B.S.; Pandit, A.; Bohara, R.A. Biofilm formation to inhibition: Role of zinc oxide-based nanoparticles. Mater. Sci. Eng. C 2020, 108, 110319. [Google Scholar] [CrossRef]
- Hajipour, M.J.; Fromm, K.M.; Ashkarran, A.A.; Jimenez de Aberasturi, D.; de Larramendi, I.R.; Rojo, T.; Serpooshan, V.; Parak, W.J.; Mahmoudi, M. Antibacterial properties of nanoparticles. Trends Biotechnol. 2012, 30, 499–511. [Google Scholar] [CrossRef]
- Shariati, A.; Dadashi, M.; Moghadam, M.T.; van Belkum, A.; Yaslianifard, S.; Darban-Sarokhalil, D. Global prevalence and distribution of vancomycin resistant, vancomycin intermediate and heterogeneously vancomycin intermediate Staphylococcus aureus clinical isolates: A systematic review and meta-analysis. Sci. Rep. 2020, 10, 12689. [Google Scholar] [CrossRef]
- Kumagai, A.; Tajima, N.; Iwamoto, S.; Morimoto, T.; Nagatani, A.; Okazaki, T.; Endo, T. Properties of natural rubber reinforced with cellulose nanofibers based on fiber diameter distribution as estimated by differential centrifugal sedimentation. Int. J. Biol. Macromol. 2019, 121, 989–995. [Google Scholar] [CrossRef]
- Blanchard, R.; Ogunsona, E.O.; Hojabr, S.; Berry, R.; Mekonnen, T.H. Synergistic cross-linking and reinforcing enhancement of rubber latex with cellulose nanocrystals for glove applications. ACS Appl. Polym. Mater. 2020, 2, 887–898. [Google Scholar] [CrossRef]
- Zhang, C.; Dan, Y.; Peng, J.; Turng, L.S.; Sabo, R.; Clemons, C. Thermal and mechanical properties of natural rubber composites reinforced with cellulose nanocrystals from southern pine. Adv. Polym. Technol. 2014, 33, 21448. [Google Scholar] [CrossRef]
- Panampilly, B.; Thomas, S. Nano ZnO as cure activator and reinforcing filler in natural rubber. Polym. Eng. Sci. 2013, 53, 1337–1346. [Google Scholar] [CrossRef]
- Oliveira, A.P.A.; Hochepied, J.-F.; Grillon, F.; Berger, M.-H. Controlled precipitation of zinc oxide particles at room temperature. Chem. Mater. 2003, 15, 3202–3207. [Google Scholar] [CrossRef]

| Ingredients | Neat NR | NR/CNF | NR/CNF-ZnO |
|---|---|---|---|
| 35% NR (g) | 100 | 100 | 100 |
| 60% Sulphur (g) | 0.7 | 0.7 | 0.7 |
| 52% ZDEC (g) | 0.6 | 0.6 | 0.6 |
| 61% ZnO (g) | 0.7 | 0.7 | 0.7 |
| Pure CNF (g) | - | 5.0 | - |
| CNF-ZnO (g) | - | - | 5.0 |
Publisher’s Note: MDPI stays neutral with regard to jurisdictional claims in published maps and institutional affiliations. |
© 2021 by the authors. Licensee MDPI, Basel, Switzerland. This article is an open access article distributed under the terms and conditions of the Creative Commons Attribution (CC BY) license (https://creativecommons.org/licenses/by/4.0/).
Share and Cite
Supramaniam, J.; Low, D.Y.S.; Wong, S.K.; Tan, L.T.H.; Leo, B.F.; Goh, B.H.; Darji, D.; Mohd Rasdi, F.R.; Chan, K.G.; Lee, L.H.; et al. Facile Synthesis and Characterization of Palm CNF-ZnO Nanocomposites with Antibacterial and Reinforcing Properties. Int. J. Mol. Sci. 2021, 22, 5781. https://doi.org/10.3390/ijms22115781
Supramaniam J, Low DYS, Wong SK, Tan LTH, Leo BF, Goh BH, Darji D, Mohd Rasdi FR, Chan KG, Lee LH, et al. Facile Synthesis and Characterization of Palm CNF-ZnO Nanocomposites with Antibacterial and Reinforcing Properties. International Journal of Molecular Sciences. 2021; 22(11):5781. https://doi.org/10.3390/ijms22115781
Chicago/Turabian StyleSupramaniam, Janarthanan, Darren Yi Sern Low, See Kiat Wong, Loh Teng Hern Tan, Bey Fen Leo, Bey Hing Goh, Dazylah Darji, Fatimah Rubaizah Mohd Rasdi, Kok Gan Chan, Learn Han Lee, and et al. 2021. "Facile Synthesis and Characterization of Palm CNF-ZnO Nanocomposites with Antibacterial and Reinforcing Properties" International Journal of Molecular Sciences 22, no. 11: 5781. https://doi.org/10.3390/ijms22115781
APA StyleSupramaniam, J., Low, D. Y. S., Wong, S. K., Tan, L. T. H., Leo, B. F., Goh, B. H., Darji, D., Mohd Rasdi, F. R., Chan, K. G., Lee, L. H., & Tang, S. Y. (2021). Facile Synthesis and Characterization of Palm CNF-ZnO Nanocomposites with Antibacterial and Reinforcing Properties. International Journal of Molecular Sciences, 22(11), 5781. https://doi.org/10.3390/ijms22115781

